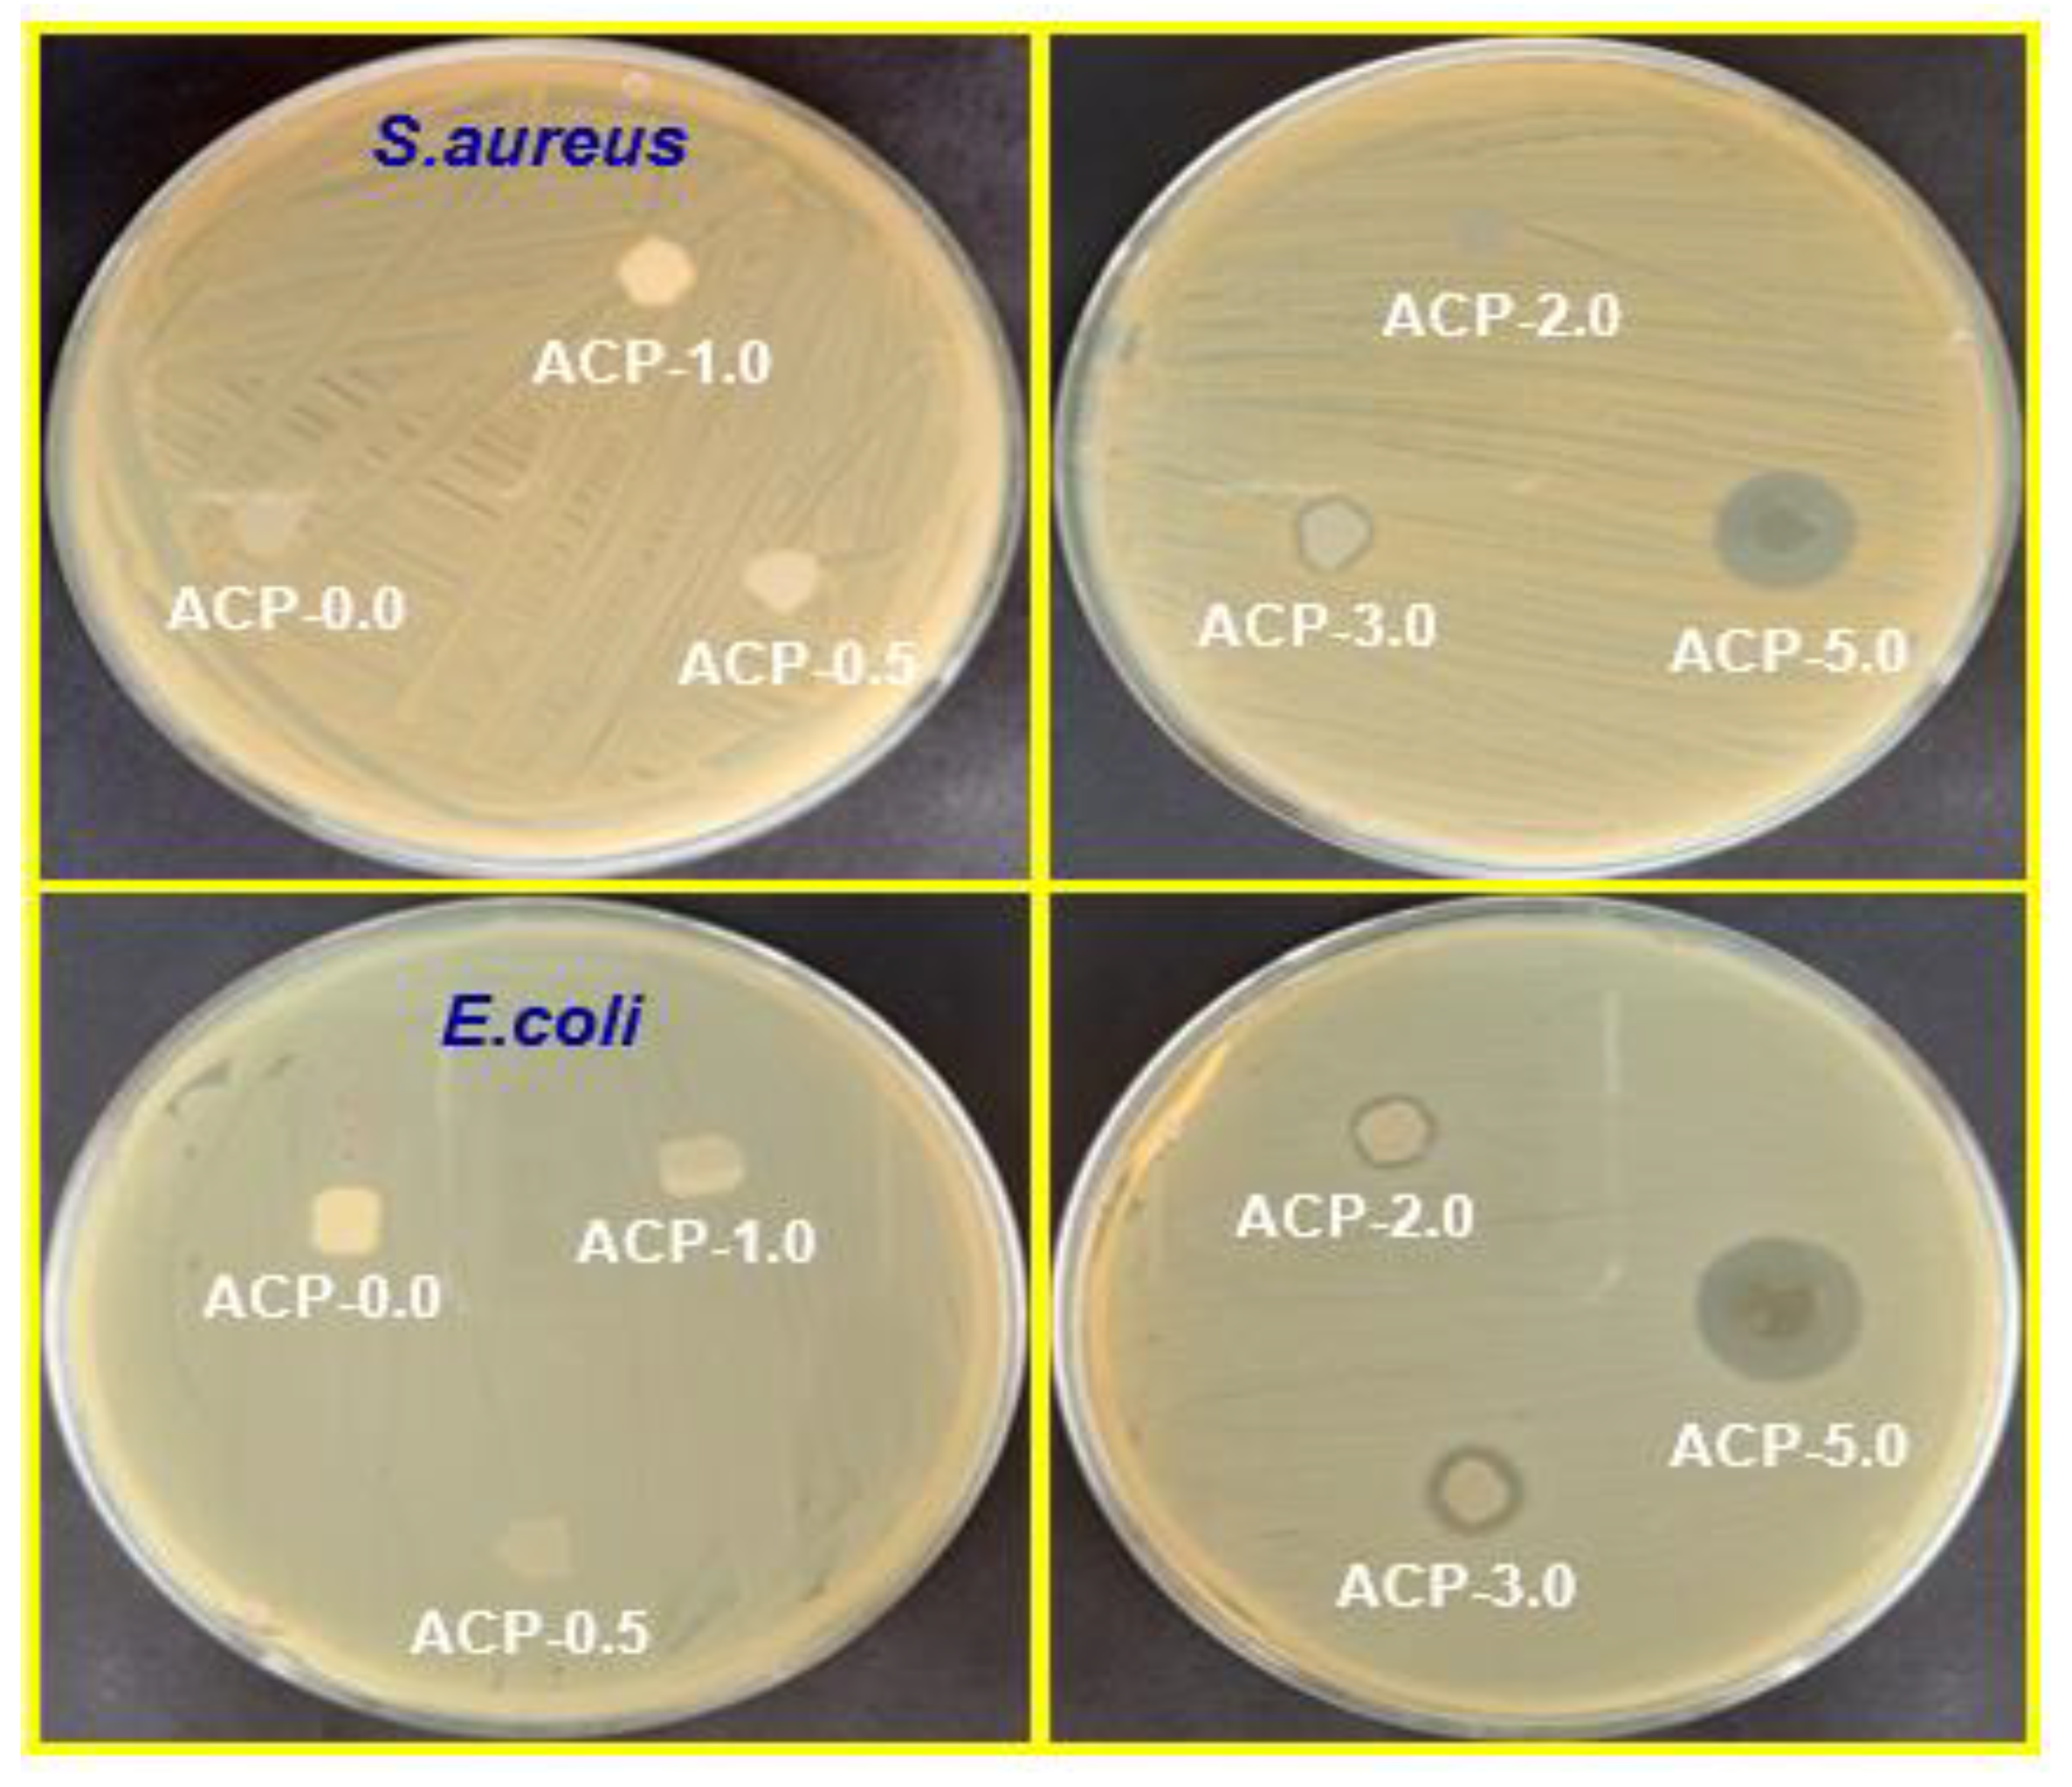
Polymers 15 00554 g012

Preparation and Performance of Biodegradable Poly(butylene adipate-co-terephthalate) Composites Reinforced with Novel AgSnO2 Microparticles for Application in Food Packaging
Abstract
1. Introduction
2. Materials and Methods
2.1. Materials
2.2. Synthesis of AgSnO2 Microparticles (MPs)
2.3. Synthesis of Poly(butylene adipate-co-terephthalate) (PBAT)
2.4. Preparation of PBAT/AgSnO2 Composite Films
2.5. Characterization
2.5.1. Structural Characterization
2.5.2. Morphological Studies
2.5.3. Thermal Characterization
2.5.4. Mechanical Strength Measurements
2.5.5. Barrier Properties
2.5.6. Water Contact Angle Measurements
2.5.7. Antimicrobial Activities
2.5.8. Soil Burial Degradation Test
2.5.9. Overall Migration Studies
2.5.10. Statistical Analysis
3. Results and Discussion
3.1. Characterization of AgSnO2 Microparticles
3.2. Characterization of PBAT copolymer
3.3. Characterization of PBAT/AgSnO2 Composites
3.3.1. Morphology and Thickness of the PBAT/AgSnO2 Composites
3.3.2. Attenuated Total Reflection Infrared (ATR-IR) Spectroscopy
3.3.3. X-ray Diffraction (XRD)
3.3.4. Scanning Electron Microscopy (SEM)
3.3.5. X-ray Photoelectron Spectroscopy Analysis (XPS)
3.3.6. Thermogravimetric (TGA) Analysis
3.3.7. Differential Scanning Calorimetry (DSC)
3.3.8. Mechanical Strength of PBAT/AgSnO2 Composites
3.3.9. Oxygen Transmission Rate (OTR)
3.3.10. Water Vapor Transmission Rate (WVTR)
3.3.11. Water Contact Angle Analysis (WCA)
3.3.12. Soil Degradation of PBAT/AgSnO2 Composites
3.3.13. Evaluation of the Antimicrobial Activity of the PBAT Composites
3.3.14. Migration of the AgSnO2 Studies
3.3.15. Food Packaging Experiment
4. Conclusions
Supplementary Materials
Author Contributions
Funding
Institutional Review Board Statement
Data Availability Statement
Conflicts of Interest
References
- Leceta, I.; Guerrero, P.; Ibarburu, I.; Dueñas, M.; de la Caba, K. Characterization and antimicrobial analysis of chitosan-based films. J. Food Eng. 2013, 116, 889–899. [Google Scholar] [CrossRef]
- Sung, S.-Y.; Sin, L.T.; Tee, T.-T.; Bee, S.-T.; Rahmat, A.; Rahman, W.; Tan, A.-C.; Vikhraman, M. Antimicrobial agents for food packaging applications. Trends Food Sci. Technol. 2013, 33, 110–123. [Google Scholar] [CrossRef]
- Türe, H.; Gällstedt, M.; Hedenqvist, M.S. Antimicrobial compression-moulded wheat gluten films containing potassium sorbate. Food Res. Int. 2012, 45, 109–115. [Google Scholar] [CrossRef]
- Zhong, Y.; Song, X.; Li, Y. Antimicrobial, physical and mechanical properties of kudzu starch–chitosan composite films as a function of acid solvent types. Carbohydr. Polym. 2011, 84, 335–342. [Google Scholar] [CrossRef]
- Suppakul, P.; Miltz, J.; Sonneveld, K.; Bigger, S. Active Packaging Technologies with an Emphasis on Antimicrobial Packaging and its Applications. J. Food Sci. 2003, 68, 408–420. [Google Scholar] [CrossRef]
- Kuswandi, B. Environmental friendly food nano-packaging. Environ. Chem. Lett. 2017, 15, 205–221. [Google Scholar] [CrossRef]
- Alkan, D.; Yemenicioğlu, A. Potential application of natural phenolic antimicrobials and edible film technology against bacterial plant pathogens. Food Hydrocoll. 2016, 55, 1–10. [Google Scholar] [CrossRef]
- Tsutsumi, C.; Hayase, N.; Nakagawa, K.; Tanaka, S.; Miyahara, Y. The enzymatic degradation of commercial biodegradable polymers by some lipases and chemical degradation of them. Macromol. Symp. 2003, 197, 431–442. [Google Scholar] [CrossRef]
- Scaffaro, R.; Maio, A.; Sutera, F.; Gulino, E.F.; Morreale, M. Degradation and Recycling of Films Based on Biodegradable Polymers: A Short Review. Polymers 2019, 11, 651. [Google Scholar] [CrossRef]
- Tavares, L.B.; Ito, N.M.; Salvadori, M.C.; dos Santos, D.J.; Rosa, D.S. PBAT/kraft lignin blend inflexible laminated food pack-aging: Peeling resistance and thermal degradability. Polym. Test. 2018, 67, 169–176. [Google Scholar] [CrossRef]
- Moustafa, H.; Guizani, C.; Dupont, C.; Martin, V.; Jeguirim, M.; Dufresne, A. Utilization of Torrefied Coffee Grounds as Reinforcing Agent To Produce High-Quality Biodegradable PBAT Composites for Food Packaging Applications. ACS Sustain. Chem. Eng. 2017, 5, 1906–1916. [Google Scholar] [CrossRef]
- Cai, X.; Yang, X.; Zhang, H.; Wang, G. Aliphatic-aromatic poly(carbonate-co-ester)s containing biobased furan monomer: Synthesis and thermo-mechanical properties. Polymer 2018, 134, 63–70. [Google Scholar] [CrossRef]
- Tiimob, B.J.; Rangari, V.K.; Mwinyelle, G.; Abdela, W.; Evans, P.G.; Abbott, N.; Samuel, T.; Jeelani, S. Tough aliphatic-aromatic copolyester and chicken egg white flexible biopolymer blend with bacteriostatic effects. Food Packag. Shelf Life 2018, 15, 9–16. [Google Scholar] [CrossRef]
- Arruda, L.C.; Magaton, M.; Bretas, R.E.S.; Ueki, M.M. Influence of chain extender on mechanical, thermal and morphological properties of blown films of PLA/PBAT blends. Polym. Test. 2015, 43, 27–37. [Google Scholar] [CrossRef]
- Rahimi, S.K.; Aeinehvand, R.; Kim, K.; Otaigbe, J.U. Structure and Biocompatibility of Bioabsorbable Nanocomposites of Aliphatic-Aromatic Copolyester and Cellulose Nanocrystals. Biomacromolecules 2017, 18, 2179–2194. [Google Scholar] [CrossRef]
- Fukushima, K.; Wu, M.-H.; Bocchini, S.; Rasyida, A.; Yang, M.-C. PBAT based nanocomposites for medical and industrial applications. Mater. Sci. Eng. C 2012, 32, 1331–1351. [Google Scholar] [CrossRef]
- Li, J.; Lai, L.; Wu, L.; Severtson, S.J.; Wang, W.-J. Enhancement of water vapor barrier properties of biodegradable poly(butylene adipate-co-terephthalate) films with highly oriented organomontmorillonite. ACS Sustain. Chem. Eng. 2018, 6, 6654–6662. [Google Scholar] [CrossRef]
- Venkatesan, R.; Rajeswari, N. TiO2 nanoparticles/poly(butylene adipate-co-terephthalate) bionanocomposite films for packaging applications. Polym. Adv. Technol. 2017, 28, 1699–1706. [Google Scholar] [CrossRef]
- Venkatesan, R.; Rajeswari, N. ZnO/PBAT nanocomposite films: Investigation on the mechanical and biological activity for food packaging. Polym. Adv. Technol. 2017, 28, 20–27. [Google Scholar] [CrossRef]
- Venkatesan, R.; Rajeswari, N.; Tamilselvi, A. Antimicrobial, mechanical, barrier, and thermal properties of bio-based poly (butylene adipate-co -terephthalate) (PBAT)/Ag2O nanocomposite films for packaging application. Polym. Adv. Technol. 2018, 29, 61–68. [Google Scholar] [CrossRef]
- Venkatesan, R.; Rajeswari, N. Preparation, Mechanical and Antimicrobial Properties of SiO2/ Poly(butylene adipate-co-terephthalate) Films for Active Food Packaging. Silicon 2016, 11, 2233–2239. [Google Scholar] [CrossRef]
- Venkatesan, R.; Rajeswari, N. Poly(butylene adipate-co-terephthalate) bionanocomposites: Effect of SnO2 NPs on mechanical, thermal, morphological, and antimicrobial activity. Adv. Compos. Hybrid Mater. 2018, 1, 731–740. [Google Scholar] [CrossRef]
- Zhang, J.; Cao, C.; Zheng, S.; Li, W.; Li, B.; Xie, X. Poly (butylene adipate-co-terephthalate)/magnesium oxide/silver ternary composite biofilms for food packaging application. Food Packag. Shelf Life 2020, 24, 100487. [Google Scholar] [CrossRef]
- V, P.P.; Jaiakumar, T.; Umadevi, M.; Mayandi, J.; Sathe, G. Synergistic effect of MgO/Ag co-doping on TiO2 for efficient antibacterial agents. Mater. Lett. 2016, 184, 82–87. [Google Scholar] [CrossRef]
- Ćosović, V.; Ćosović, A.; Talijan, N.; Živković, D.; Manasijević, D.; Minić, D. Improving dispersion of SnO2 nanoparticles in Ag–SnO2 electrical contact materials using template method. J. Alloy. Compd. 2013, 567, 33–39. [Google Scholar] [CrossRef]
- Jingqin, W.; Ying, Z.; Huiling, K. Study on properties of AgSnO2contact materials doped with rare earth Y. Mater. Res. Express 2018, 5, 085902. [Google Scholar] [CrossRef]
- Wang, J.; Xu, J.; Zhu, Y.; Hu, D.; Lu, N.; Cui, D.; Guo, P. Properties of AgSnO2 Contact Materials Doped with Different Concentrations of Cr. Materials 2022, 15, 4793. [Google Scholar] [CrossRef] [PubMed]
- Suganthi, S.; Mohanapriya, S.; Raj, V.; Kanaga, S.; Dhandapani, R.; Vignesh, S.; Sundar, J.K. Tunable Physicochemical and Bactericidal Activity of Multicarboxylic-Acids-Crosslinked Polyvinyl Alcohol Membrane for Food Packaging Applications. Chem. Select 2018, 3, 11167–11176. [Google Scholar] [CrossRef]
- Li, G.; Shankar, S.; Rhim, J.-W.; Oh, B.-Y. Effects of preparation method on properties of poly(butylene adipate-co-terephthalate) films. Food Sci. Biotechnol. 2015, 24, 1679–1685. [Google Scholar] [CrossRef]
- Yang, T.-Z.; Du, Z.-J.; Gu, Y.-Y.; Qiu, X.-Y.; Jiang, M.-X. Preparation of AgSnO2 composite powders by hydrothermal process. J. Central South Univ. Technol. 2007, 14, 176–180. [Google Scholar] [CrossRef]
- Alagumalai, K.; Shanmugam, R.; Chen, S.-M.; Chen, T.-W.; Al-Mohaimeed, A.M.; Al-Onazi, W.A.; Elshikh, M.S. Dual-mode electrochemical evaluation of 8-hydroxy-5-nitroquinoline in industrial sewage. Surfaces Interfaces 2021, 23, 101019. [Google Scholar] [CrossRef]
- Paek, K.H.; Im, S.G. Biodegradable Aromatic–Aliphatic Copolyesters Derived from Bis(2-Hydroxyethyl) Terephthalate for Sustainable Flexible Packaging Applications. ACS Appl. Polym. Mater. 2022, 4, 5298–5307. [Google Scholar] [CrossRef]
- Zhu, K.; Zhu, W.-P.; Gu, Y.-B.; Shen, Z.-Q.; Chen, W.; Zhu, G.-X. Synthesis and Characterization of Poly(butylene adipate-co- terephthalate) Catalyzed by Rare Earth Stearates. Chin. J. Chem. 2007, 25, 1581–1583. [Google Scholar] [CrossRef]
- Venkatesan, R.; Zhang, Y.; Chen, G. Preparation of poly(butylene adipate-co-terephthalate)/ZnSnO3 composites with enhanced antimicrobial activity. Compos. Commun. 2020, 22, 100469. [Google Scholar] [CrossRef]
- Venkatesan, R.; Vanaraj, R.; Alagumalai, K.; Asrafali, S.P.; Raorane, C.J.; Raj, V.; Kim, S.-C. Thermoplastic Starch Composites Reinforced with Functionalized POSS: Fabrication, Characterization, and Evolution of Mechanical, Thermal and Biological Activities. Antibiotics 2022, 11, 1425. [Google Scholar] [CrossRef]
- Balaji, S.; Venkatesan, R.; Mugeeth, L.; Dhamodharan, R. Hydrophobic nanocomposites of PBAT with Cl-fn-POSS nanofiller as compostable food packaging films. Polym. Eng. Sci. 2021, 61, 314–326. [Google Scholar] [CrossRef]
- Liu, Y.; Liu, S.; Liu, Z.; Lei, Y.; Jiang, S.; Zhang, K.; Yan, W.; Qin, J.; He, M.; Qin, S.; et al. Enhanced mechanical and biodegradable properties of PBAT/lignin composites via silane grafting and reactive extrusion. Compos. Part B Eng. 2021, 220, 108980. [Google Scholar] [CrossRef]
- Li, W.; Huang, J.; Liu, W.; Qiu, X.; Lou, H.; Zheng, L. Lignin modified PBAT composites with enhanced strength based on interfacial dynamic bonds. J. Appl. Polym. Sci. 2022, 27, e52476. [Google Scholar] [CrossRef]
- Fukushima, K.; Rasyida, A.; Yang, M.-C. Characterization, degradation and biocompatibility of PBAT based nanocomposites. Appl. Clay Sci. 2013, 80, 291–298. [Google Scholar] [CrossRef]
- Espinoza-Martínez, A.; Avila-Orta, C.; Cruz-Delgado, V.; Olvera-Neria, O.; González-Torres, J.; Medellín-Rodríguez, F. Nucleation Mechanisms of Aromatic Polyesters, PET, PBT, and PEN, on Single-Wall Carbon Nanotubes: Early Nucleation Stages. J. Nanomater. 2012, 9, 189820. [Google Scholar] [CrossRef]
- Cazón, P.; Morales-Sanchez, E.; Velazquez, G.; Vázquez, M. Measurement of the water vapor permeability of chitosan films: A laboratory experiment on food packaging materials. J. Chem. Educ. 2022, 99, 2403–2408. [Google Scholar] [CrossRef]
- Radhakrishnan, S.; Thorat, S.; Desale, A.; Desai, P.; Kulkarni, M. Structure and Properties of PBS/PBAT blends and nanocomposites. IOP Conf. Series Mater. Sci. Eng. 2022, 1248, 012013. [Google Scholar] [CrossRef]
- Rasyida, A.; Fukushima, K.; Yang, M.-C. Structure and properties of organically modified poly(butylene adipate-co-terephthalate) based nanocomposites. IOP Conf. Series Mater. Sci. Eng. 2016, 223, 012023. [Google Scholar] [CrossRef]
- Xiong, S.-J.; Pang, B.; Zhou, S.-J.; Li, M.-K.; Yang, S.; Wang, Y.-Y.; Shi, Q.; Wang, S.-F.; Yuan, T.-Q.; Sun, R.-C. Economically Competitive Biodegradable PBAT/Lignin Composites: Effect of Lignin Methylation and Compatibilizer. ACS Sustain. Chem. Eng. 2020, 8, 5338–5346. [Google Scholar] [CrossRef]
- Bae, H.J.; Park, H.J.; Hong, S.I.; Byun, Y.J.; Darby, D.O.; Kimmel, R.M.; Whiteside, W.S. Effect of clay content, homogenization RPM, pH, and ultrasonication on mechanical and barrier properties of fish gelatin/montmorillonite nanocomposite films. LWT Food Sci. Technol. 2009, 42, 1179–1186. [Google Scholar] [CrossRef]
- Nayak, S.K. Biodegradable PBAT/Starch Nanocomposites. Polym. Technol. Eng. 2010, 49, 1406–1418. [Google Scholar] [CrossRef]
- Seligra, P.G.; Moura, L.E.; Famá, L.; Druzian, J.I.; Goyanes, S. Influence of incorporation of starch nanoparticles in PBAT/TPS composite films. Polym. Int. 2016, 65, 938–945. [Google Scholar] [CrossRef]
- Kim, J.-H.; Lee, J.C.; Kim, G.-H. Study on poly(butylene adipate-co-terephthalate)/starch composites with polymeric methylenediphenyl diisocyanate. J. Appl. Polym. Sci. 2015, 132, 41884. [Google Scholar] [CrossRef]
- Shi, L.; Kang, L.; Gong, J.; Zhang, X.; Liao, J.; Mo, L.; Li, J. Cellulose nanofibrils reinforced films without chemical modification, hydrophobic, high elongation, and foldability. Ind. Crop. Prod. 2022, 180, 114742. [Google Scholar] [CrossRef]
- Morelli, C.L.; Belgacem, M.N.; Branciforti, M.C.; Salon, M.C.B.; Bras, J.; Bretas, R.E.S. Nanocomposites of PBAT and cellulose nanocrystals modified by in situ polymerization and melt extrusion. Polym. Eng. Sci. 2016, 56, 1339–1348. [Google Scholar] [CrossRef]
- Yang, Y.; Zhang, C.; Weng, Y. Effects of CaCO3 surface modification and water spraying on the weathering properties of PBAT/CaCO3 films. Polym. Test. 2021, 102, 107334. [Google Scholar] [CrossRef]
- Rocha, D.B.; de Carvalho, J.S.; de Oliveira, S.A.; Rosa, D.D.S. A new approach for flexible PBAT/PLA/CaCO3films into agriculture. J. Appl. Polym. Sci. 2018, 135, 46660. [Google Scholar] [CrossRef]
- Xu, D.; Xiong, Z.; Xia, C.; Xiong, H. Effects of nano-TiO2 on the structure and properties of composite materials constructed from eggshell powder/poly(butyleneadipate-co-terephthalate). J. Appl. Polym. Sci. 2022, 139, 52251. [Google Scholar] [CrossRef]
- Someya, Y.; Sugahara, Y.; Shibata, M. Nanocomposites based on poly(butylene adipate-co-terephthalate) and montmorillonite. J. Appl. Polym. Sci. 2005, 95, 386–392. [Google Scholar] [CrossRef]
- Bumbudsanpharoke, N.; Ko, S. Nano-Food Packaging: An Overview of Market, Migration Research, and Safety Regulations. J. Food Sci. 2015, 80, R910–R923. [Google Scholar] [CrossRef]
- Störmer, A.; Bott, J.; Kemmer, D.; Franz, R. Critical review of the migration potential of nanoparticles in food contact plastics. Trends Food Sci. Technol. 2017, 63, 39–50. [Google Scholar] [CrossRef]
- Echegoyen, Y.; Nerín, C. Nanoparticle release from nano-silver antimicrobial food containers. Food Chem. Toxicol. 2013, 62, 16–22. [Google Scholar] [CrossRef]
- Metak, A.M.; Nabhani, F.; Connolly, S.N. Migration of engineered nanoparticles from packaging into food products. Lwt Food Sci. Technol. 2015, 64, 781–787. [Google Scholar] [CrossRef]
- Indumathi, M.; Sarojini, K.S.; Rajarajeswari, G. Antimicrobial and biodegradable chitosan/cellulose acetate phthalate/ZnO nano composite films with optimal oxygen permeability and hydrophobicity for extending the shelf life of black grape fruits. Int. J. Biol. Macromol. 2019, 132, 1112–1120. [Google Scholar] [CrossRef]
- Chi, H.; Song, S.; Luo, M.; Zhang, C.; Li, W.; Li, L.; Qin, Y. Effect of PLA nanocomposite films containing bergamot essential oil, TiO2 nanoparticles, and Ag nanoparticles on shelf life of mangoes. Sci. Hortic. 2019, 249, 192–198. [Google Scholar] [CrossRef]
- Venkatesan, R.; Alagumalai, K.; Raorane, C.J.; Raj, V.; Shastri, D.; Kim, S.-C. Morphological, Mechanical, and Antimicrobial Properties of PBAT/Poly(methyl methacrylate-co-maleic anhydride)–SiO2 Composite Films for Food Packaging Applications. Polymers 2022, 15, 101. [Google Scholar] [CrossRef] [PubMed]

| S. No | Samples | TGA | DSC | Ash Content (%) b | |
|---|---|---|---|---|---|
| Final Degradation Temperature (°C) a | Tg (°C) | Tm (°C) | |||
| 1. | ACP-0.0 | 416.00 | −33.2 | 125.38 | 6.20 |
| 2. | ACP-0.5 | 417.33 | −34.0 | 127.50 | 5.91 |
| 3. | ACP-1.0 | 418.20 | −35.4 | 128.45 | 5.85 |
| 4. | ACP-2.0 | 419.75 | −36.9 | 129.81 | 5.50 |
| 5. | ACP-3.0 | 421.05 | −38.2 | 130.24 | 5.24 |
| 6. | ACP-5.0 | 425.80 | −40.7 | 132.55 | 4.75 |
| S. No | Composition of PBAT/AgSnO2 Composites (wt.%) | OTR (cc/m2/day.atm) | WVTR (g/m2/day) |
|---|---|---|---|
| 1. | 100/0.0 | 1104.62 ± 3.40 a | 124.54 ± 2.96 a |
| 2. | 99.5/0.5 | 1062.59 ± 2.01 a | 119.59 ± 2.28 a |
| 3. | 99.0/1.0 | 1002.58 ± 2.74 c | 108.45 ± 3.15 c |
| 4. | 98.0/2.0 | 961.15 ± 3.05 a | 96.57 ± 2.71 c |
| 5. | 97.0/3.0 | 857.62 ± 2.55 b | 77.72 ± 3.40 a |
| 6. | 95.0/5.0 | 688.25 ± 1.81 c | 48.67 ± 2.20 a |
| Concentration in Packaging Materials | Matrix | Test Procedure | Analytical Methods | Migration Amount (mg/L) |
|---|---|---|---|---|
| AgSnO2 (20.0 mg/L) | PBAT film | The composite was exposed to the simulant for 2 h at −2 °C. | ICP-MS | SnO2 = 407 Ag < 0.21 |
| PBAT film | The composite was exposed to the simulant for 2 h at 0 °C. | ICP-MS | SnO2 = 355 Ag < 0.15 |
Disclaimer/Publisher’s Note: The statements, opinions and data contained in all publications are solely those of the individual author(s) and contributor(s) and not of MDPI and/or the editor(s). MDPI and/or the editor(s) disclaim responsibility for any injury to people or property resulting from any ideas, methods, instructions or products referred to in the content. |
© 2023 by the authors. Licensee MDPI, Basel, Switzerland. This article is an open access article distributed under the terms and conditions of the Creative Commons Attribution (CC BY) license (https://creativecommons.org/licenses/by/4.0/).
Share and Cite
Venkatesan, R.; Alagumalai, K.; Kim, S.-C. Preparation and Performance of Biodegradable Poly(butylene adipate-co-terephthalate) Composites Reinforced with Novel AgSnO2 Microparticles for Application in Food Packaging. Polymers 2023, 15, 554. https://doi.org/10.3390/polym15030554
Venkatesan R, Alagumalai K, Kim S-C. Preparation and Performance of Biodegradable Poly(butylene adipate-co-terephthalate) Composites Reinforced with Novel AgSnO2 Microparticles for Application in Food Packaging. Polymers. 2023; 15(3):554. https://doi.org/10.3390/polym15030554
Chicago/Turabian StyleVenkatesan, Raja, Krishnapandi Alagumalai, and Seong-Cheol Kim. 2023. "Preparation and Performance of Biodegradable Poly(butylene adipate-co-terephthalate) Composites Reinforced with Novel AgSnO2 Microparticles for Application in Food Packaging" Polymers 15, no. 3: 554. https://doi.org/10.3390/polym15030554
APA StyleVenkatesan, R., Alagumalai, K., & Kim, S.-C. (2023). Preparation and Performance of Biodegradable Poly(butylene adipate-co-terephthalate) Composites Reinforced with Novel AgSnO2 Microparticles for Application in Food Packaging. Polymers, 15(3), 554. https://doi.org/10.3390/polym15030554

